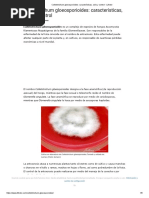

100% encontró este documento útil (1 voto)
846 vistas2 páginasMapa Conceptual TEMA 4
Este documento describe el desarrollo hormonal en las plantas, incluyendo la germinación, crecimiento vegetativo, floración, polinización, fecundación y maduración de los frutos. Explica que estas etapas están reguladas por fitohormonas como auxinas, giberelinas, citocininas, etileno y ácido abscísico. También cubre las respuestas de las plantas al ambiente, patógenos, herbívoros, suelos, temperatura y salinidad.
Cargado por
Lorenzo Albaladejo RodriguezDerechos de autor
© © All Rights Reserved
Nos tomamos en serio los derechos de los contenidos. Si sospechas que se trata de tu contenido, reclámalo aquí.
Formatos disponibles
Descarga como PDF, TXT o lee en línea desde Scribd
100% encontró este documento útil (1 voto)
846 vistas2 páginasMapa Conceptual TEMA 4
Este documento describe el desarrollo hormonal en las plantas, incluyendo la germinación, crecimiento vegetativo, floración, polinización, fecundación y maduración de los frutos. Explica que estas etapas están reguladas por fitohormonas como auxinas, giberelinas, citocininas, etileno y ácido abscísico. También cubre las respuestas de las plantas al ambiente, patógenos, herbívoros, suelos, temperatura y salinidad.
Cargado por
Lorenzo Albaladejo RodriguezDerechos de autor
© © All Rights Reserved
Nos tomamos en serio los derechos de los contenidos. Si sospechas que se trata de tu contenido, reclámalo aquí.
Formatos disponibles
Descarga como PDF, TXT o lee en línea desde Scribd